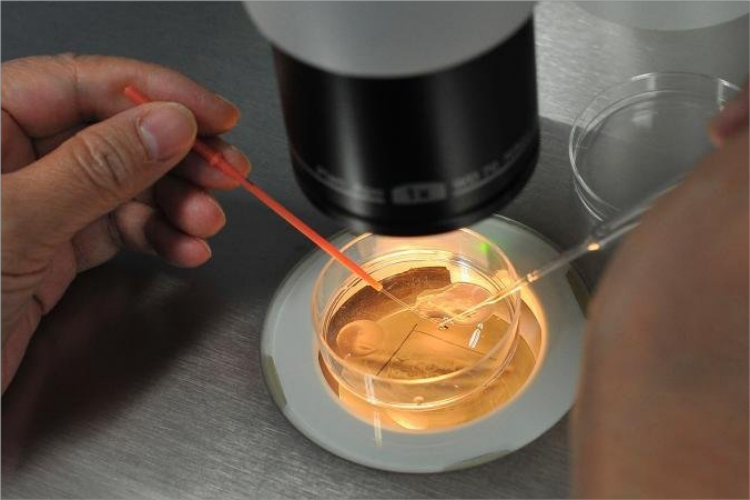
寻找卵冠丘复合体图

概述
取卵手术多采用经阴道超声阴道下穿刺取卵的方法,其过程包括常规术前准备、确定进针位置并抽吸卵泡、寻找卵冠丘复合体。
过程
取卵手术的过程有常规术前准备、确定进针位置并抽吸卵泡、寻找卵冠丘复合体,需由专业人员操作。
常规术前准备:患者取膀胱截石位,进行常规消毒,铺巾,局部麻醉镇痛。

确定进针位置并抽吸卵泡:放入阴道探头及穿刺架,彻底扫描盆腔,了解子宫、卵巢的位置和可及度,并确定进针位置后,用单腔取卵针抽吸卵泡液。

寻找卵冠丘复合体:抽吸的卵泡液由胚胎实验室由技术人员,在体式显微镜下寻找卵冠丘复合体。并记录取卵时间,对所回收卵母细胞质量及胚胎质量进行评分。
适应症
取卵手术适用于体外受精胚胎移植治疗中卵母细胞获取者。有禁忌的为阴道急性炎症期、盆腔急性炎症期、凝血功能障碍等人群。
参考文献
[1]王晓宁,江成龙,刁红录.经阴道穿刺取卵手术时间与妊娠结局的分析[J].重庆医学.2019.38.
[2]姜玉新.超声科[M].中国医药科技出版社.2014.578.
展开
